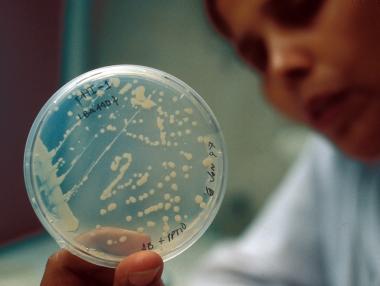
Бактерия на Витоша е по-ценна от златото

Откриват една от метростанциите в София по-рано
Първоначалният срок беше 31 юли

Бягайте от панелките, посъветва бизнесменът Христо Чепишев

Тя съчетава удобство и уют с модерен дизайн и изискан интериор

За момента не е ясно и какво е предизвикало инцидента
Тя може да излекува инвалидност, рак или слепота

Футуристична кристална сграда може да заеме мястото на взривения преди години хотел

Ремонтът приключи по-рано от предвидения срок

Отварят специализирана автобусна линия до хижа „Алеко”

Средствата са използвани и за зони за отдих на мечки и вълци и туристически пътеки

Официалното откриване на ски сезона ще се състой от 18:00

Във втория от поредицата ни фоторепортажи ви представяме луксозните композиции „Корона“ и „Витоша“ експрес на Български държавни железници. Подробен материал за атракционните пътувания с железницата
С нощно каране ще бъде открит ски сезона на Витоша тази събота, 21 декември. Това обявиха концесионерите от "Витоша ски".
Сигналът е подаден от общинския съветник Георги Кадиев